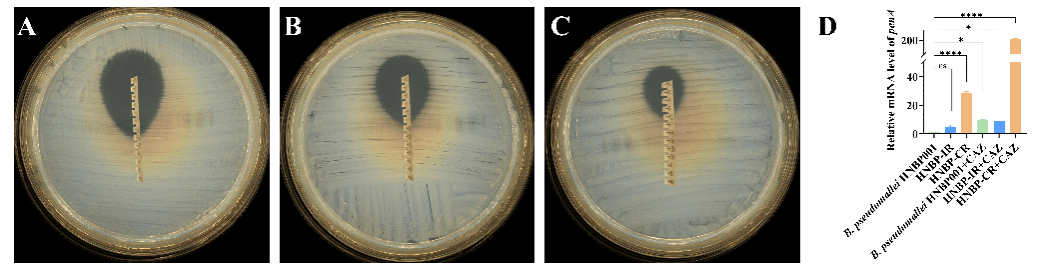

科研速递:《Drug Resistance Updates(耐药性更新)》丨我校科研团队揭示海南类鼻疽伯克霍尔德菌头孢他啶耐药分子机制
7月10日,热带医学院夏乾峰教授团队在《Drug Resistance Updates》在线发表题为“Point mutation P174L of the penA gene endowing ceftazidime resistance to Burkholderia pseudomallei in China”的论文。

类鼻疽是由类鼻疽伯克霍尔德菌(以下简称Bp)感染导致的热带病,海南不仅是国内相关病例最集中的省份,临床数据还显示本地Bp的耐药性显著高于其他疫区,背后所涉及的分子机制和调控网络亟待探明。
该课题组与三亚市人民医院检验科陈海主任合作,以临床Bp头孢他啶耐药株为实验对象,经全基因组测序发现,相比于野生型,耐药株中编码A型β内酰胺酶基因(penA)的539位胞嘧啶突变为胸腺嘧啶,从而导致氨基酸序列上的脯氨酸转变为亮氨酸。继续对耐药株中的penA进行敲除,或将含点突变的penA引入野生型Bp,证明该点突变可导致菌株的头孢他啶耐药能力上升,推测是该突变导致了PenA蛋白的保守区产生了更加适合水解头孢他啶的构象改变。研究人员同时注意到单一的penA点突变无法让菌株达到临床耐药株相一致的头孢他啶耐药能力,为此还进行了相关基因的转录分析,发现耐药株中还存在penA的高表达,并在头孢他啶的刺激下,penA的转录水平会进一步提高。该研究合理推测海南Bp的耐药率异常可能是头孢他啶作用下,penA的高表达导致了少部分菌株转化为耐受或持留菌得以存活,一旦penA又出现特殊的点突变(如上述的539位胞嘧啶突变为胸腺嘧啶),最终Bp会在治疗过程中表现出头孢他啶耐药。
该成果以海南医科大学为唯一通讯单位,热带医学院田申老师、吴兴勇硕士、刘琳老师、厉安洋硕士为论文共同第一作者,夏乾峰教授为通讯作者。本研究受到国家自然科学基金、海南省重点研发计划、海南省自然科学基因等项目资助。